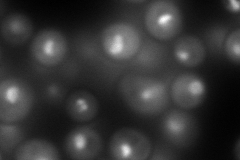
YJR063W
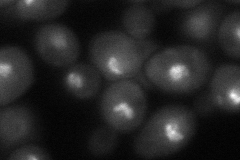
YJR063W
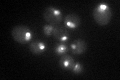
YJR063W

View description
RNA polymerase I subunit A12.2; contains two zinc binding domains, and the N terminal domain is responsible for anchoring to the RNA pol I complex
Localization:
Intensity:
Fold change:
Significance:
-
C’ GFP library in SD

nucleolus177.53 -
N' NOP1pr-GFP in SD

nucleolus168.147 -
N' TEF2pr-mCherry in SD
nucleolus235.881 -
N' NATIVEpr-GFP in SD

nucleolus104.783 -
N' TEF2pr-VC and Cyto-VN in SD
punctate58.6432 -
C’ GFP library in SD+DTT

nucleolus123.170.69No -
C’ GFP library in SD+H2O2

nucleolus110.530.62No -
C’ GFP library in Starvation Media
nucleolus69.910.39Yes -
C’ GFP library on the background of Pup2-DaMP

nucleolus -
C’ GFP library on the background of CCT mutant

nucleolus137.1540.772528No
